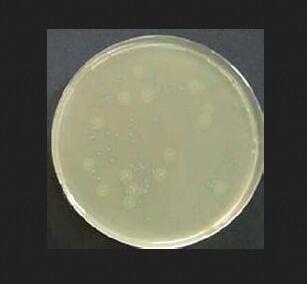
MPC琼脂培养基

MPC琼脂培养基
询价
250g
起订
山东 更新日期:2026-04-05
产品详情:
- 中文名称:
- MPC琼脂培养基
- 产品类别:
- 细胞培养基
公司简介
青岛捷世康生物科技有限公司位于美丽的海滨城市青岛。总公司由留美博士创建,致力于国内实验室试剂的研发,并与美国、德国、澳大利亚、日本等多家顶尖生物及研究单位建立了密切的合作关系,产品辐射国内二十多个省份近千家科研院所。公司集技术研发、产品生产、产品销售,技术服务于一体,致力于“为创造性生产提供高质量产品服务”,产品品质有幸得到了国内广大科研工作者的高度认可,在业内积累了良好的口碑。
公司主营业务:国产/进口ELISA检测试剂盒、国产/进口抗体,两千余种中草药对照品和生物染液等产品,涵盖了细胞实验、分子实验、WB、IHC等试验所用一切产品,为客户科研项目提供一站式采购服务。公司同时接受客户的WB、IHC、ELISA代测和试剂定制合成提纯业务,欢迎来电咨询洽谈。
| 成立日期 | (12年) |
| 注册资本 | 100.000000万 |
| 员工人数 | 1-10人 |
| 年营业额 | ¥ 100万以内 |
| 经营模式 | 贸易 |
| 主营行业 | 细胞培养 |
MPC琼脂培养基相关厂家报价 更多
-

- MPC琼脂培养基
- 上海哈灵生物科技有限公司
- 2026-04-05
- 询价
-

- MPC琼脂培养基 微生物培养基-CN230695
- 阿勒山(广州)生物科技有限公司
- 2022-10-13
- ¥160
-

- CFAT琼脂培养基基础
- 上海宾穗生物科技有限公司 VIP
- 2026-04-05
- ¥711
-
![LB琼脂固体粉末培养基[Miller]](https://img.chemicalbook.com/SupplyImg/2021-11-03/Large/202111031013501669074.jpg)
- LB琼脂固体粉末培养基[Miller]
- 上海冠导生物工程有限公司 VIP
- 2026-04-05
- 询价
-

- 90mm大豆酪蛋白琼脂琼脂培养基(TSA)(β-内酰胺酶)
- 南京乐诊生物技术有限公司
- 2026-04-05
- 询价